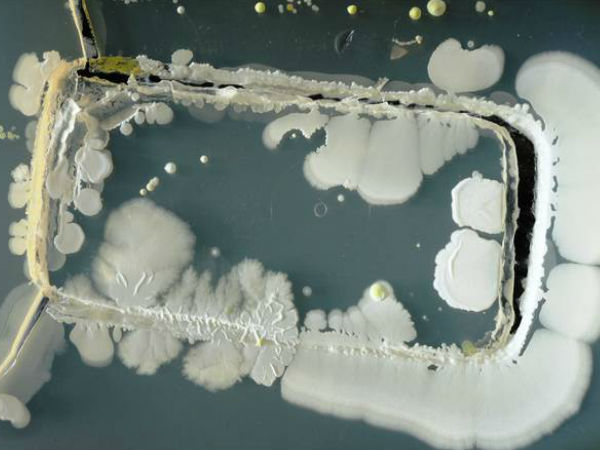
రోగోలను వ్యాప్తిచేసే బ్యాక్టీరియా..

మన జీవితాన్ని మొబైల్ ఈ విధంగా నాశనం చేస్తుందని తెలుసా ?
స్మార్ట్ఫోన్ లేకుండా ఒక్క నిమిషం కూడా జీవించిలేని పరిస్థితి ప్రస్తుత సమాజంలో నెలకుంది.
స్మార్ట్ఫోన్ లేకుండా ఒక్క నిమిషం కూడా జీవించిలేని పరిస్థితి ప్రస్తుత సమాజంలో నెలకుంది. ఇందుకు కారణం రోజురోజుకు పెరిగిపోతోన్న కమ్యూనికేషన్ అవసరాలే. శక్తివంతమైన కమ్యూనికేషన్ సాధనాల్లో ఒకటైన స్మార్ట్ఫోన్ మనుషుల ఆరోగ్యాలతో కూడ ఆటలాడుకుంటోందని నిపుణులు హెచ్చిరిస్తున్నారు. ఫోన్ వాడకం విపరీతంగా మారితే మనుషుల్లో కొత్త కొత్త రోగాలు వస్తాయని వారు హెచ్చిస్తున్నారు. సోషల్ మీడియా ఎక్కువైన నేపథ్యంలో జాగ్రత్తగా ఉండాలని చెబుతున్నారు. మితిమీరిన మొబైల్ ఫోన్ వినియోగం కారణంగా తలెత్తే పలు ఆరోగ్య సమస్యలను ఇప్పుడు తెలుసుకుందాం..

చేతి వేళ్లు, మణికట్లు దెబ్బ తినే ప్రమాదం
స్మార్ట్ఫోన్ ద్వారా నిరంతరాయంగా స్ర్కోలింగ్, టెక్స్టింగ్, గేమింగ్ చేయటం వల్ల మీ చేతి వేళ్లు దెబ్బ తినే ప్రమాదముంది.

వెన్నెముక పై ఒత్తిడి
మితమీరిన స్మార్ట్ఫోన్ వినియోగం బ్యాక్ పెయిన్ అలానే వెన్నెముక ఒత్తిడికి దారితీస్తుందని వైద్యులు హెచ్చిరిస్తున్నారు.

కళ్ల పై తీవ్రమైన ఒత్తిడి
మితమీరిన స్మార్ట్ఫోన్ వినియోగం కళ్ల పై ఒత్తిడిని తీసుకురావటంతో పాటు ప్రమాదకర తలనొప్పులకు దారితీస్తుంది. అంతేకాకుండా మితమీరిన స్మార్ట్ఫోన్ వినియోగం స్లీపింగ్ డిసార్డర్ను కూడా పెంచుతుందని వైద్యులు హెచ్చరిస్తున్నారు. తద్వారా నిద్ర కొరవడే ప్రమాదముంది.
రోగోలను వ్యాప్తిచేసే బ్యాక్టీరియా..
మీకు తెలుసా! మీ చేతిలోని ఫోన్, టాయిలెట్ సీట్ పై ఉండే బ్యాటరీ కంటే 10 రెట్లు ఎక్కువైన బ్యాక్టీరియాను కలిగి ఉంటుంది. కాబట్టి స్మార్ట్ఫోన్ల వల్ల రోగాలు కూడా వ్యాపించే ప్రమాదముంది.

హానికర రేడియోషన్
స్మార్ట్ఫోన్ల ద్వారా వెలువడే రేడియోషన్ పుట్టబోయే పిల్లల పై తీవ్ర ప్రభావం చూపే అవకాశాలు ఉన్నాయి.ఫోన్ రేడియేషన్ చిన్నపిల్లల పైనే కాదు మీ మేథోశక్తి పై కూడా ప్రభావం చూపే అవకాశం.

గుండె పనితీరు పై ప్రభావం..
మితమీరిన స్మార్ట్ఫోన్ వినియోగం మీ గుండె పనతీరు పై కూడా ప్రభావం చూపే అవకాశముందని ఇటీవల ఓ యూరోపియన్ జర్నల్ ఓ నివేదికను విడుదల చేసింది.

ఒక్కోసారి మరణం కూడా తప్పదు
నాసికరం స్మార్ట్ఫోన్లు, చార్జర్లు పేలుడుకు దారితీస్తాయి. ఇలాంటి సందర్బాల్లో ఒక్కోసారి మరణం కూడా తప్పదు.


Click it and Unblock the Notifications